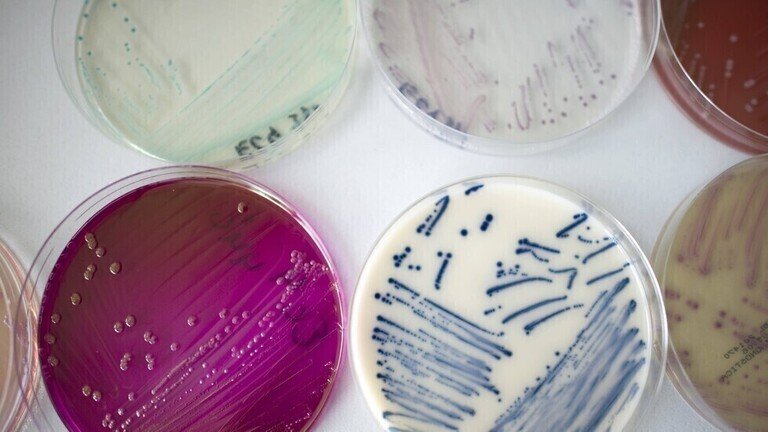

تقدم دراسة جديدة أدلة على أصول مسببات الأمراض الفطرية القاتلة المقاومة للمضادات الحيوية، والتي ظهرت بشكل غامض في المستشفيات حول العالم منذ 10 سنوات.
وتؤرخ الدراسة اكتشاف العامل الممرض لأول مرة في بيئة طبيعية نائية وتبني على فرضية متنامية بأن الاحترار العالمي قد يحفز تطور هذه التهديدات الفطرية الجديدة.
وتوصل الباحثون لأول مرة إلى أثر الفطريات القاتلة المقاومة لمعظم أشكال العلاج، في جزيرة استوائية في المحيط الهندي.
ومن المعروف أن فطر داء البقع البيضاء أو فطر الكانديدا أوريس (candida auris)، هي المسؤولة عن تفشي الأمراض المعدية في جميع أنحاء العالم ووصفت بأنها “تهديد خطير للصحة العالمية”.
واكتشف العلماء العامل الممرض في البرية لأول مرة بعد 11 عاما من إصابته مريضا في اليابان.
وتشرح الدراسة الجديدة التي نُشرت في مجلة mBio، كيف تتبع الباحثون فطر داء البقع البيضاء (Candida auris) في موقعين في جزر أندمان في خليج البنغال.
وكان العامل الممرض مسؤولا عن تفشي المرض في جميع أنحاء العالم، مع أكثر من 1600 حالة في الولايات المتحدة منذ 19 يناير من هذا العام. وحتى الآن، ما زال مصدر الفطر لغزا طبيا.
ووقعت تسمية فطر داء البقع البيضاء لأول مرة، بعد إصابة مريض في اليابان عام 2009، على الرغم من التعرف عليه لأول مرة في عام 1996 في كوريا الجنوبية، وبعد ذلك تم اكتشافه بسرعة في ثلاث قارات أخرى.
ووصفت المراكز الأمريكية لمكافحة الأمراض والوقاية منها (CDC) في عام 2019 العامل الممرض بأنه “فطر ناشئ يمثل تهديدا خطيرا للصحة العالمية”.
والمخاوف المحيطة بالفطر ثلاثية الأبعاد ولكنها تتوقف على قدرته على تحمل معظم أشكال العلاج.
وفي بعض الحالات، أظهرت سلالات العامل الممرض قدرة ملحوظة على مقاومة جميع الفئات المتاحة من مضادات الفطريات.
وقد يكون من الصعب تحديد الفطر إلى حد ما، ما قد يؤدي إلى خطأ في التعرف عليه، وعلاجه بشكل خاطئ.
وتفشي العامل الممرض في المستشفيات يعني أنه يجب اتخاذ احتياطات خاصة لمنع انتشاره، مثل الفيروس التاجي إلى حد كبير.
ويمكن أن تكون العدوى قاتلة، حيث تقدر مراكز السيطرة على الأمراض أن ما بين 30 إلى 60 مريضا أصيبوا بالفطر قد ماتوا.
ومع ذلك، فإن البيانات المتاحة محدودة والعديد من المرضى يعانون بالفعل من حالات كامنة خطيرة.
وقالت مراكز السيطرة على الأمراض والوقاية منها: “يمكن علاج معظم حالات عدوى فطر داء البقع البيضاء بفئة من الأدوية المضادة للفطريات تسمى echinocandins. ومع ذلك، فإن بعض حالات عدوى فطر داء البقع البيضاء تقاوم الفئات الرئيسية الثلاثة من الأدوية المضادة للفطريات، ما يجعل علاجها أكثر صعوبة”.
ويمكن أن ينتشر العامل الممرض من خلال ملامسته للأسطح الملوثة والمعدات الطبية وحتى بين البشر.
ووفقا للبحث الجديد، تم العثور سابقا على أنواع مرتبطة ارتباطا وثيقا بالفطر في البرية.
وقال الدكتور أرتورو كاساديفال من كلية جونز هوبكنز بلومبرغ للصحة العامة في بالتيمور، الذي كتب افتتاحية مرفقة بالدراسة: “إنه لغز طبي، من أين أتى”.




